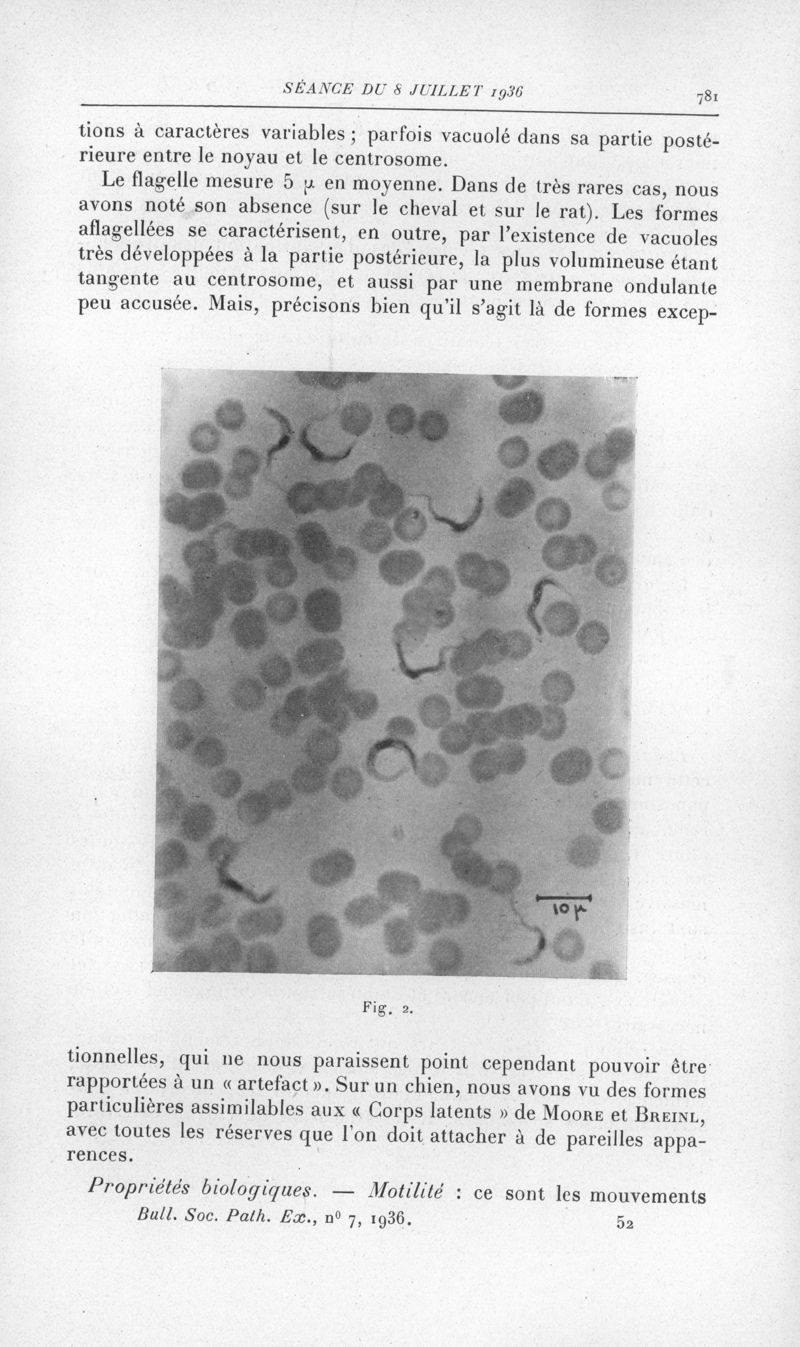

Présentation • Mode d’emploi • Services associés • Réutilisations
|
1936, tome 29. -
Paris : Masson,
1936.
|
|
URL pérenne de cette page : https://www.biusante.parisdescartes.fr/histmed/medica/page?bspex1936&p=753
|
|
1936, tome 29. -
Paris : Masson,
1936.
|